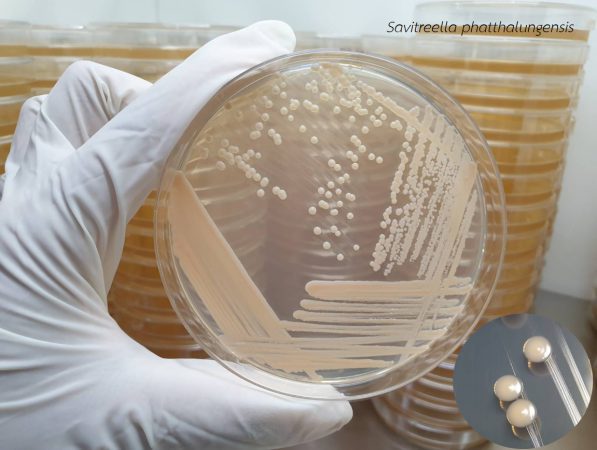

คณะนักวิจัย ม.เกษตรศาสตร์ ม.ทักษิณ และ ม.ราชภัฏนครปฐม
ค้นพบยีสต์สกุลใหม่ 1 สกุล และชนิดใหม่ของโลก 2 ชนิด จากผิวใบสับปะรด
พบครั้งแรกที่จังหวัดพัทลุง และ จังหวัดชลบุรี ประเทศไทย

คณะวิจัย ประกอบด้วย นักวิจัยมหาวิทยาลัยเกษตรศาสตร์ ดร.พัณณิดา ขุนนามวงษ์ อาจารย์ประจำ ภาควิชาจุลชีววิทยา คณะวิทยาศาสตร์ มหาวิทยาลัยเกษตรศาสตร์ ร่วมกับ ดร.ภูมิน นุตรทัต อาจารย์ประจำ สาขาชีววิทยา คณะวิทยาศาสตร์ มหาวิทยาลัยทักษิณ และ ดร.วนัชพร บุญธรรม อาจารย์ประจำ สาขาวิชาจุลชีววิทยา คณะวิทยาศาสตร์และเทคโนโลยี มหาวิทยาลัยราชภัฏนครปฐม ได้ค้นพบยีสต์สกุลใหม่ของโลก 1 สกุล คือ สกุล Savitreella และยีสต์ชนิดใหม่ของโลก 2 ชนิด ได้แก่ Savitreella phatthalungensis และ Goffeauzyma siamensis จากผิวใบสับปะรดซึ่งเก็บตัวอย่างที่อำเภอป่าบอน จังหวัดพัทลุง และ อำเภอศรีราชา จังหวัดชลบุรี ภายใต้โครงการ “เหมืองข้อมูลและคลังทรัพยากรจุลินทรีย์เพื่อการใช้ประโยชน์ในอุตสาหกรรมการเกษตรและอาหาร (FF(KU) 18.64)” โดยมี รศ. ดร.นันทนา สีสุข ภาควิชาจุลชีววิทยา คณะวิทยาศาสตร์ มหาวิทยาลัยเกษตรศาสตร์ เป็นหัวหน้าโครงการ และ ศ. ดร.สาวิตรี ลิ่มทอง ภาควิชาจุลชีววิทยา คณะวิทยาศาสตร์ มหาวิทยาลัยเกษตรศาสตร์ เป็นที่ปรึกษาโครงการ ซึ่งโครงการวิจัยนี้ได้รับทุนสนับสนุนวิจัยด้านวิทยาศาสตร์ วิจัยและนวัตกรรม ทุนสนับสนุนงานพื้นฐาน ประจำปีงบประมาณ 2564 ผ่านทางมหาวิทยาลัยเกษตรศาสตร์ โดยมีวัตถุประสงค์เพื่อพัฒนานักวิจัยรุ่นใหม่ให้มีความเชี่ยวชาญด้านความหลากหลายทางชีวภาพของจุลินทรีย์ในประเทศไทย และการจัดทำฐานข้อมูลจุลินทรีย์ที่มีศักยภาพด้านอุตสาหกรรมการเกษตรและอาหาร

ดร.พัณณิดา ขุนนามวงษ์ อาจารย์ประจำ ภาควิชาจุลชีววิทยา คณะวิทยาศาสตร์ มหาวิทยาลัย เกษตรศาสตร์ กล่าวว่า ทีมนักวิจัยทั้ง 3 คน ได้ศึกษาความหลากหลายของยีสต์บนผิวใบสับปะรดและนำยีสต์ที่แยกได้มาค้นหาสายพันธุ์ที่มีศักยภาพสำหรับใช้ประโยชน์ในอุตสาหกรรมการเกษตรและอาหาร สาเหตุที่เลือกแยกยีสต์จากผิวใบสับปะรด เนื่องจากคาดว่า ใบสับปะรดซึ่งมีความเป็นกรดเล็กน้อย เป็นแหล่งที่มีสารอาหารและมีสภาวะที่เหมาะสมต่อการเจริญของยีสต์ และยีสต์ที่สามารถเจริญบนใบสับปะรดได้น่าจะมีศักยภาพในการผลิตสารที่สำคัญที่สามารถนำไปประยุต์ใช้ในการเกษตรและอาหารต่อไป
ทีมนักวิจัยได้ลงพื้นที่สำรวจและเก็บตัวอย่างยีสต์บนผิวใบสับปะรด ที่อำเภอป่าบอน จังหวัดพัทลุง และ อำเภอศรีราชา จังหวัดชลบุรี โดยแยกได้ยีสต์จำนวนมาก และกำหนดรหัสสายพันธุ์ของยีสต์ที่แยกได้เป็น DMKU-PAL (DMKU ย่อมาจาก Department of Microbiology, Kasetsart University และ PAL มาจากคำว่า pineapple leave) เมื่อนำมาระบุชนิด โดยอนุกรมวิธานระดับโมเลกุล ด้วยการวิเคราะห์ลำดับนิวคลีโอไทด์ของยีนสำหรับการจำแนกยีสต์ พบว่ามียีสต์ 4 สายพันธุ์ คือ สายพันธุ์ DMKU-PAL186, DMKU-PAL178, DMKU-PAL18 และ DMKU-PAL39 มีลำดับนิวคลีโอไทด์ของยีนสำหรับการจำแนกยีสต์ ไม่ตรงกับของยีสต์ชนิดใด ๆ ที่รู้จักแล้วทั่วโลก
และเมื่อนำยีสต์ทั้ง 4 สายพันธุ์ มาศึกษาเพิ่มเติมตามหลักการของอนุกรมวิธานฟอลิฟลาสิก (polyphasic taxonomy) ซึ่งประกอบด้วย การศึกษาลักษณะของรูปร่าง ชีวเคมี และสรีวิทยา และการวิเคราะห์ลำดับนิวคลีโอไทด์ของยีนบางยีนเพิ่มเติม พร้อมทั้งวิเคราะห์ความสัมพันธ์ทางวิวัฒนาการของยีสต์ที่ค้นพบร่วมกับยีสต์ชนิดที่รู้จักแล้วที่ใกล้เคียง
สรุปได้ว่า ยีสต์สายพันธุ์ DMKU-PAL186 และ DMKU-PAL178 เป็นยีสต์ชนิดเดียวกัน และเป็นยีสต์สกุลใหม่และชนิดใหม่ของโลก จึงตั้งชื่อสกุลใหม่ว่า Savitreella เพื่อให้เกียรติแด่ ศาสตราจารย์ ดร.สาวิตรี ลิ่มทอง ผู้เชี่ยวชาญด้านอนุกรมวิธานยีสต์ในระดับโลก และด้านความหลากหลายและเทคโนโลยีชีวภาพยีสต์ในประเทศไทย และตั้งชื่อสปีชีส์ใหม่ว่า Savitreella phatthalungensis เนื่องจากยีสต์ชนิดใหม่นี้ค้นพบครั้งแรกที่จังหวัดพัทลุง ส่วนสายพันธุ์ DMKU-PAL18 และ DMKU-PAL39 เป็นยีสต์ชนิดเดียวกัน และเป็นยีสต์ชนิดใหม่ของโลก จึงตั้งชื่อสปีชีส์ใหม่นี้ว่า Goffeauzyma siamensis โดยคำว่า “Siam” เป็นชื่อเดิมของประเทศไทย เพื่อต้องการบ่งบอกว่าชนิดใหม่นี้ค้นพบครั้งแรกที่ประเทศไทย โดยการค้นพบยีสต์สกุลใหม่ 1 สกุล และชนิดใหม่ 2 ชนิดนี้ได้ตีพิมพ์ในวารสารวิชาการระดับนานาชาติ Journal of Fungi เมื่อเดือน มกราคม 2022
ดร.พัณณิดา ขุนนามวงษ์ กล่าวเพิ่มเติมอีกว่า โครงการวิจัยนี้นอกจากจะศึกษาความหลากหลายของยีสต์แล้วยังมุ่งเน้นการค้นหายีสต์สายพันธุ์ที่มีศักยภาพในการผลิตแคโรทีนอยด์เพื่อนำไปใช้ในอุตสาหกรรมอาหาร และการผลิตสารอินทรีย์ระเหยง่ายที่มีฤทธิ์ยับยั้งราก่อโรค เพื่อใช้ควบคุมโรคพืชแทนการใช้สารเคมีทางการเกษตร
จากการค้นพบยีสต์ชนิดใหม่นี้สนับสนุนว่าประเทศไทยมีความหลากหลายทางชีวภาพสูง ยีสต์ที่พบในประเทศไทยเหล่านี้เป็นทรัพยากรจุลินทรีย์ที่มีศักยภาพสำหรับการนำไปใช้ประโยชน์ทางด้านการเกษตรและอาหาร ข้อมูลเหล่านี้จะนำไปสู่การจัดการทรัพยากรที่มีอยู่ได้อย่างมีประสิทธิภาพ และยั่งยืน นอกจากนั้นการเก็บรักษาเชื้อยีสต์เหล่านี้ไว้ในคลังทรัพยากรจุลินทรีย์จะเพิ่มโอกาสให้นักวิจัยนำไปศึกษาศักยภาพในด้านต่าง ๆ เพื่อการใช้ประโยชน์ด้านอื่น ๆ ต่อไป การวิจัยนี้จึงเป็นก้าวแรกที่สำคัญของนักวิจัยที่จะมีโอกาสได้ค้นพบยีสต์ที่มีศักยภาพที่จะนำมาต่อยอดในการสร้างเป็นผลิตภัณฑ์ใหม่ ๆ เพื่อช่วยแก้ไขปัญหา และส่งเสริมเกษตรกรไทย และนำไปต่อยอดเพื่อยกระดับงานวิจัยในระดับอุตสาหกรรมที่สามารถผลักดันให้ประเทศชาติเข้าสู่การพัฒนาเชิงเศรษฐกิจฐานชีวภาพและการเกษตรได้
ข้อมูลอ้างอิง
Nutaratat, P., Boontham. W. and Khunnamwong, P. 2022. A novel yeast genus and two novel species isolated from pineapple leaves in Thailand: Savitreella phatthalungensis gen. nov., sp. nov. and Goffeauzyma siamensis sp. nov. J. 8(2), 118; https://doi.org/10.3390/jof8020118
ข่าวโดย ผกามาศ ธนพัฒนพงศ์ / หัวหน้างานประชาสัมพันธ์ / มหาวิทยาลัยเกษตรศาสตร์
